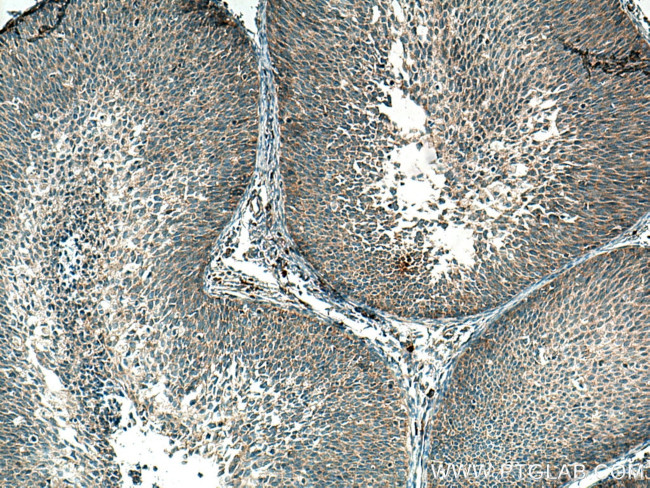
CSAD Antibody in Immunohistochemistry (Paraffin) (IHC (P))

Search
Proteintech
CSAD Polyclonal Antibody
{{$productOrderCtrl.translations['antibody.pdp.commerceCard.promotion.promotions']}}
{{$productOrderCtrl.translations['antibody.pdp.commerceCard.promotion.viewpromo']}}
{{$productOrderCtrl.translations['antibody.pdp.commerceCard.promotion.promocode']}}: {{promo.promoCode}} {{promo.promoTitle}} {{promo.promoDescription}}. {{$productOrderCtrl.translations['antibody.pdp.commerceCard.promotion.learnmore']}}
产品信息
22870-1-AP
种属反应
宿主/亚型
分类
类型
抗原
偶联物
形式
浓度
规格
纯化类型
保存液
内含物
保存条件
运输条件
产品详细信息
Immunogen sequence: DVALDTGDK VVQCGRRVDC LKLWLMWKAQ GDQGLERRID QAFVLARYLV EEMKKREGFE LVMEPEFVNV CFWFVPPSLR GKQESPDYHE RLSKVAPVLK ERMVKEGSMM IGYQPHGTRG NFFRVVVANS ALTCADMDFL LNELERLGQD L (344-493 aa encoded by BC098278)
靶标信息
This gene encodes a member of the group 2 decarboxylase family. A similar protein in rodents plays a role in multiple biological processes as the rate-limiting enzyme in taurine biosynthesis, catalyzing the decarboxylation of cysteinesulfinate to hypotaurine. Alternatively spliced transcript variants encoding multiple isoforms have been observed for this gene.
仅用于科研。不用于诊断过程。未经明确授权不得转售。
篇参考文献 (0)
生物信息学
蛋白别名: Aspartate 1-decarboxylase; Cysteine sulfinic acid decarboxylase; cysteine sulfinic acid decarboxylase-related protein; Cysteine-sulfinate decarboxylase; P-selectin cytoplasmic tail-associated protein; Sulfinoalanine decarboxylase; unnamed protein product
基因别名: CSAD; CSD; PCAP
UniProt ID: (Human) Q9Y600, (Rat) Q64611, (Mouse) Q9DBE0
Entrez Gene ID: (Human) 51380, (Rat) 60356, (Mouse) 246277